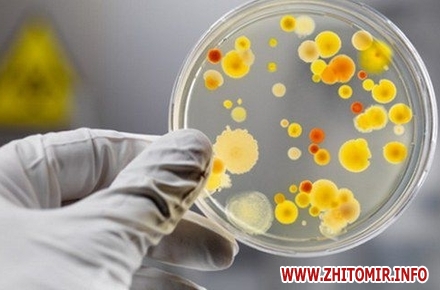

Вінницька лабораторія зробивши аналізи виявила у житомирській гімназії №23 ще один вірус – ентеровірус.
Про це Житомир.info розповів заступник Житомирського міського голови Матвій Хренов.
«Вінницька лабораторія виявила ентеровірус зробивші необхідні аналізи. Я тільки що обдзвонив лікарні – все добре. Я ще раз підкреслюю, діти на вірусні інфекції, харчові, хворіють постійно. Щодо ситуації по №23 школі – діти вже всі виписані з лікарні. Є також інформація, що ще з однієї школи поступило двоє дітей: у однієї вірусна інфекція, у іншої бактеріальна», - сказав Матвій Хренов.
Довідково: Ентеровіруси – це гострі інфекційні захворювання, збудниками яких служать кишкові віруси (ентеровіруси) з сімейства пікорнавірусів. Клінічні прояви ентеровірусної інфекції у дітей є поліморфними. Захворювання може протікати в наступних формах: катаральній, гастроентеритичній, ентеровірусної лихоманки, ентеровірусної екзантеми, герпангіни, серозного менінгіту, міокардиту, енцефаломіокардиту новонароджених, кон’юнктивіту, увеїту та ін. Джерелами ентеровірусної інфекції можуть служити діти і дорослі, які є вірусоносіями або хворими маніфестною формою захворювання. Передача інфекції від людини до людини здійснюється повітряно-крапельним або фекально-оральним шляхами.
Нагадаємо, на «кишковий грип» захворіли учні ще однієї житомирської школи, батьки бояться спалаху.
Як повідомляв Житомир.info, 24 січня Матвій Хренов назвав причину масового захворювання учнів Житомирської міської гуманітарної гімназії №23: ротавірусна інфекція. Нагадаємо, 21 січня 13 учнів різних класів гімназії були госпіталізовані з ознаками харчового отруєння. З понеділка, 30 січня, навчання у гімназії відновлюється.
























